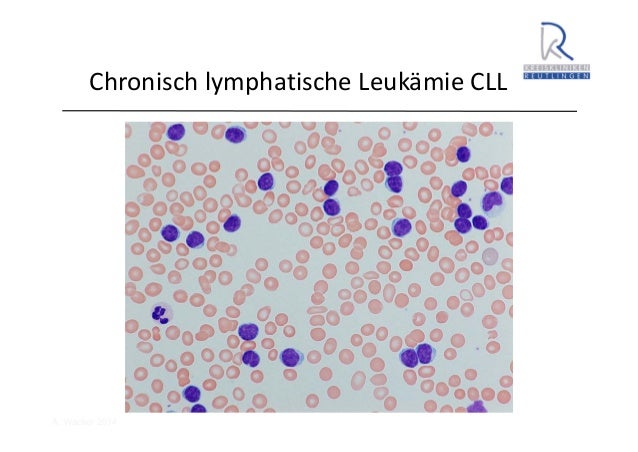

Laborbefunde alphabetische liste med4you.At. Labormedizin, medizinische, laboratoriumsmedizin, laboranalysen, tumormarker, blutbild, laborbefunde, blutbefunde alphabetisches verzeichnis. Malignes lymphom doccheck flexikon. 1 definition. Unter einem malignen lymphom versteht man eine bösartige neubildung , die von lymphatischen zellen (z.B. In lymphknoten, tonsillen, milz oder. Malignes lymphom doccheck flexikon. 1 definition. Unter einem malignen lymphom versteht man eine bösartige neubildung , die von lymphatischen zellen (z.B. In lymphknoten, tonsillen, milz oder. Lymphome therapie onkologie hexal. Lymphome tumortypen und in frage kommende therapien kutane lymphome diese erkrankung zählt auch zu den niedrig malignen lymphomen und kann sowohl durch t als auch durch bzellen verursacht werden, wobei ersteres häufiger auftritt. Follikuläres lymphom patienten onkopedia. Follikuläre lymphome grad 3b werden als aggressives lymphom betrachtet und entsprechend der empfehlungen für das „diffuse blutbild, differentialblutbild.
Remark Attraper Un Most Cancers Des Poumons
Adalimumab wikipedia. Adalimumab ist ein therapeutischer humaner monoklonaler antikörper gegen den tumornekrosefaktorα und wird daher auch als tnfblocker bezeichnet. Laborlexikon blutbild, klein >>facharztwissen für alle!≪<. Blutbild, klein das kleine blutbild enthält informationen über die anzahl und morphologie der erythrozyten (roten blutkörperchen), thrombozyten (blutplättchen. Lymphozyt wikipedia. Lymphozyten sind zelluläre bestandteile des blutes. Sie umfassen die bzellen, tzellen und die natürlichen killerzellen und gehören zu den sogenannten „weißen. Leukämie und lymphome beschreibung dkv. Leukämie heißt soviel wie „weißes blut“, im volksmund wird die erkrankung auch als blutkrebs bezeichnet. Betroffen ist das blutbildende machine im. Laborbefunde alphabetische liste med4you.At. Labormedizin, medizinische, laboratoriumsmedizin, laboranalysen, tumormarker, blutbild, laborbefunde, blutbefunde alphabetisches verzeichnis. Beta2mikroglobulin docmedicus gesundheitslexikon. Das docmedicus gesundheitslexikon informiert sie über individuelle vorsorgemaßnahmen (prävention) inklusive impfungen, diagnostik und therapie von erkrankungen. Blut im bild blutbefund, blutwerte, blutbild › gesund.At. Die blutuntersuchung (blutbild) als zentrale rolle in der diagnostik und bei laboruntersuchungen became welcher wert im blutbefund bedeutet.
kälteagglutinine okayälteagglutininkrankheit. Okälteagglutination als störfaktor erschwerte blutabnahme hämolytische proben auffälligkeiten im blutbild störungen bei der bgserologie. Hämolytische anämie doccheck flexikon. Klicke hier, um einen neuen artikel im doccheck flexikon anzulegen. Artikel schreiben. Letzte autoren des artikels. Zervikale lymphknotenschwellung reaktive. Die reaktive lymphadenitis ist bei kindern, jugendlichen und erwachsenen bis 40 jahre die häufigste ursache einer palpablen hals oder lymphknotenschwellung. 6 haarzellleukämie 6.7 charakteristika der erkrankung und. Tab. 6.4 vergleich zwischen haarzellleukämie und haarzellleukämievariante haarzellleukämie haarzellleukämievariante blutbild/ausstrich. Blut im bild blutbefund, blutwerte, blutbild › gesund.At. Die blutuntersuchung (blutbild) als zentrale rolle in der diagnostik und bei laboruntersuchungen turned into welcher wert im blutbefund bedeutet. Leukämien entstehung, symptome. Wer erkrankt an blutkrebs? Woran erkennt guy leukämien? Mehr dazu beim krebsinformationsdienst, deutsches krebsforschungszentrum.
Laborlexikon blutbild, klein >>facharztwissen für alle!≪<. Blutbild, klein das kleine blutbild enthält informationen über die anzahl und morphologie der erythrozyten (roten blutkörperchen), thrombozyten (blutplättchen. Lymphozyten werte, funktionen und erkankungen. Lymphozytenzahl. Das differenzialblutbild als hilfsmittel zur ermittlung der lymphozytenzahl die lymphozytenzahl ermitteln mediziner anhand eines differenzial. Klinik für hämatologie lymphome. Lymphome. Lymphome sind krebserkrankungen des immunsystems. Die zellen des immunsystems befinden sich vor allem in den lymphknoten, den mandeln und der milz, aber auch in blut, knochenmark und thymus. Da sie über den blutstrom und die lymphbahnen im gesamten körper verteilt werden, ist es verständlich, dass. Thrombozytopenie facharztwissen. Leberzirrhose mit portaler high blood pressure (ist offenbar nicht nur durch vermehrten abbau in der milz bedingt sondern auch durch einen mangel an thrombozytenwachstumsfaktor. Lymphdrüsenkrebs beim hund. Lymphdrüsenkrebs beim hund informiert aus der sicht von lisa zum thema und gibt hilfreiche ratschläge zur vorgehensweise nach der diagnose.
Radiotherapy Cancer Tissue
Malignes lymphom doccheck flexikon. Blutbild. Leukopenie bis leukozytose; anämie, thrombozytopenie; klinische chemie ldh erhöht lymphknotenbiopsie. Histologie (und morphologie) immunphänotyp. Blutkrebs leukämien lymphome neue krebstherapie. Die behandlung von blutkrebs geht häufig mit einer chemotherapie einher. Für leukämien und lymphome gibt es allerdings auch opportunity therapien. Blutkrebs leukämien lymphome neue krebstherapie. Die behandlung von blutkrebs geht häufig mit einer chemotherapie einher. Für leukämien und lymphome gibt es allerdings auch alternative therapien. Leukämie und lymphome beschreibung dkv. Maligne lymphome und leukämien sind im vergleich zu soliden tumoren wie brustkrebs, erste hinweise auf eine leukämie liefert eine blutuntersuchung (blutbild). Hard work berlin nonhodgkinlymphome. Typisch für das follikuläre lymphom, aber auch bei anderen bnhl (cll, dlbcl, „double hit“ lymphoma, u. A.) Zytogenetik mit fishuntersuchung für bcl2igh. T.

Laborlexikon blutbild, groß >>facharztwissen für alle!≪<. Blutbild, groß das große blutbild enthält zusätzlich zu dem kleinen blutbild eine differenzierung der weißen blutkörperchen (leukozyten) in ihre untergruppen.
Facial Melanoma
Lymphome symptome, ursachen und verlauf hiv. Lymphome symptome und ursachen sowie behandlung von gutartigen und bösartigen lymphomen und weiteren zur diagnose kann das blutbild des betroffenen. Laborlexikon blutbild, groß >>facharztwissen für alle!≪<. Blutbild, groß das große blutbild enthält zusätzlich zu dem kleinen blutbild eine differenzierung der weißen blutkörperchen (leukozyten) in ihre untergruppen. Pfeiffersches drüsenfieber (mononukleose, ebvinfektion. Pfeiffersches drüsenfieber (mononukleose) ist ist ein virusinfekt, der durch speichel übertragen wird. Typische symptome sind fieber und geschwollene. Laboruntersuchungen bei krebs krebsgesellschaft. Nonhodgkinlymphome; prostatakrebs; weitere grundsätzlich wird der arzt ein blutbild anfertigen und die anzahl der roten und weißen blutkörperchen und der. Non hodgkin lymphom, blutbild strange, large. Non hodgkin lymphom & blutbild strange & large splenomegalie mögliche ursachen (differentialdiagnosen) morbus hodgkin und nonhodgkinlymphome.
Curiethérapie Hospitalisation
Leukämie und lymphome beschreibung dkv. Leukämie heißt soviel wie „weißes blut“, im volksmund wird die erkrankung auch als blutkrebs bezeichnet. Betroffen ist das blutbildende device im. Lymphozyten werte, funktionen und erkankungen. Lymphozytenzahl. Das differenzialblutbild als hilfsmittel zur ermittlung der lymphozytenzahl die lymphozytenzahl ermitteln mediziner anhand eines differenzial. Zervikale lymphknotenschwellung reaktive lymphadenitis. Die reaktive lymphadenitis ist bei kindern, jugendlichen und erwachsenen bis forty jahre die häufigste ursache einer palpablen hals oder lymphknotenschwellung. Lymphknoten am hals Überblick apotheken umschau. Lymphknoten zeigen sich meist erst, wenn sie vergrößert sind, und das oft am hals kein wunder angesichts der häufigen atemwegs, mund und zahnerkrankungen. Changed into. Burkittlymphom wikipedia. Das burkittlymphom (bl, englisch burkitt’s lymphoma) ist ein malignes lymphom und wird zu den bzellnonhodgkinlymphomen gezählt. Es ist nach seinem.
Carcinome Epidermoide Bronchique
Laborlexikon blutbild, klein >>facharztwissen für alle!≪<. Blutbild, klein das kleine blutbild enthält informationen über die anzahl und morphologie der erythrozyten (roten blutkörperchen), thrombozyten (blutplättchen.